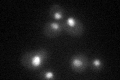
YOR189W
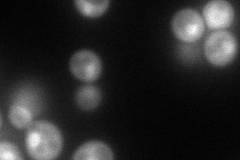
YOR189W
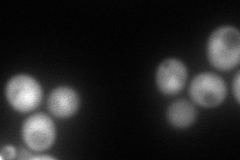
YOR189W

View description
Component of the INO80 chromatiin remodeling complex and target of the Mec1p/Tel1p DNA damage signaling pathway; proposed to link chromatin remodeling to replication checkpoint responses
Localization:
Intensity:
Fold change:
Significance:
-
C’ GFP library in SD
nucleus37.75 -
N' NOP1pr-GFP in SD
cytosol,nucleus139.726 -
N' TEF2pr-mCherry in SD
cytosol175.429 -
N' NATIVEpr-GFP in SD

nucleus48.2668 -
N' TEF2pr-VC and Cyto-VN in SD

#N/A0 -
C’ GFP library in SD+DTT

nucleus44.831.18No -
C’ GFP library in SD+H2O2

nucleus46.81.23No -
C’ GFP library in Starvation Media

nucleus46.881.24No -
C’ GFP library on the background of Pup2-DaMP

nucleus -
C’ GFP library on the background of CCT mutant

nucleus31.18240.825792No
